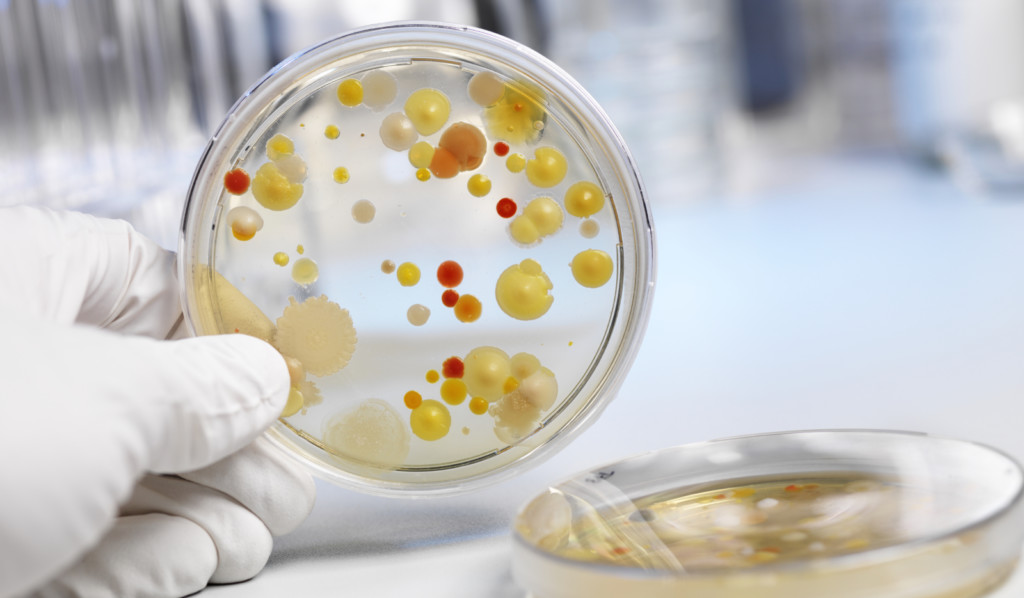

Зачем чистят параанальные железы
Околоанальные железы представляют собой специфический парный орган, располагающийся в области выхода из прямой кишки. Протоки параанальных желез выходят сразу в области анального отверстия. Эти железы продуцируют специфический, ярко пахнущий секрет, необходимый животным для распознавания другу друга в стае, привлечения половых партнеров или же разметки территориальных границ.
Физиологически нормально работающие железы самостоятельно опустошаются в процессе акта дефекации. В некоторых случаях, секрет может «вылетать» во время активных физических нагрузок у животного или же при испытании собакой сильного стресса.
Порой, параанальные железы закупориваются и не могут самостоятельно опорожниться. Сужение протоков или же появление сгустков в специфической жидкости, продуцируемой железой, может вызывать воспаление.
Спровоцировать изменение в составе секрета околоанальных желез, могут различные факторы. Причинами способны послужить – неправильный рацион питания, отсутствие половой активности, проникновение патогенных бактериальных микроорганизмов в железу, неправильный уход за питомцев. Воспаление в области параанальных желез диагностируются у различных собак, но в группе риска находятся собаки карликовых и декоративных пород.
Признаками развития воспаления в параанальных железах у собаки, становятся:
- сильный зуд в области анального отверстия – собака начинает активно покусывать себя под хвостом, может стараться ездить на попе по твердым и шершавым поверхностям (считается, что подобное поведение характерно для гельминтозов, на самом деле, причиной служит воспаление в области параанальных желез);
- выраженный болевой синдром – собака при попытках владельца дотронутся к хвосту или крупу, проявляет беспокойство, а порой и агрессию;
- появление отталкивающего запаха от животного, особенно когда оно поворачивается хвостом к владельцу.
При возникновении вышеперечисленных симптомов, необходимо провести чистку желез при помощи мягкого надавливания на железу.
В условиях ветеринарной клиники провести процедуру значительно проще и безопасней. Специалист проведет не только очистку желез, но и осуществит санацию специальными растворами антисептика. Рекомендуется после чистки ввести в анальное отверстие свечку с противовоспалительным эффектом.
Если очистку околоанальных желез не провести вовремя, патологический процесс может осложниться присоединением патогенной бактериальной микрофлоры, характеризующееся скоплением гноя и развитием абсцесса.
При разрыве абсцесса может возникнуть свищ. Без хирургического вмешательства не обойтись. Если у питомца осложнение воспалительного процесса в параанальных железах, проводят очистку желез, ставят дренаж и промывают антисептическими растворами. Назначаются специальные мази и свечи с противовоспалительным эффектом. Необходимо назначение курса противомикробных средств.
Воспаление параанальных желез у кошек: лечение

Воспалительный процесс называют парапроктитом. В зависимости от тяжести процесса проводят консервативное лечение, заключающееся в чистке или промывании пораженных резервуаров или удаление пораженного органа оперативным путем.
Чистка параанальных желез у кошек
Если заболевание не запущено помогает процедура очистки мешков. Для этого нет необходимости везти животное в клинику. Освобождение параанальных желез от экссудата выполнит вызванный на дом ветеринарный врач или опытный фелинолог. Если при пальпации выясняется, что содержимое патологической полости жидкое, применяют наружный метод.
Манипуляцию проводят вдвоем, в спецодежде, очках и перчатках. Животное заносят в ванную комнату. Ассистент надежно фиксирует животное при помощи полотенца. Оператор накрывает воспаленные железы марлевой салфеткой и выдавливает содержимое двумя пальцами.
Когда приходится иметь дело с твердым экссудатом, применяют метод ректальной санации. В прямую кишку вводят указательный палец. Его нащупываю снаружи большим и аккуратно массируют. Таким способом освобождают железы от вязкого содержимого.
После удаления экссудата железы обрабатывают мазью содержащей хлорамфеникол или Мирамистином либо спреем, содержащим хлоргексидин. В анус вставляют четвертинку антисептического противовоспалительного суппозитория. Следят, чтобы кошка не вытолкнула лекарство. Для предотвращения слизывания надевают на полчаса шейный воротник или смыкают челюсти тесьмой.
Промывание параанальных желёз
Процедуру проводит ветеринарный специалист в условиях клиники. Она необходима в тяжелой ситуации, на стадии формирования абсцесса или образования свища. Попытка очистить парааналки описанным выше способом не удается, манипуляция сопровождается сильной болью.

Обязательно почитайте:
Водянка у кошек – асцит брюшной полости: можно ли вылечить, как спасти кота
После удаления экссудата через катетер внутрь желез вводят раствор антисептика. При необходимости формируют дренажное отверстие. Процедуру проводят под местной анестезией. Вводят ректальные противовоспалительные свечи. Назначают системные антибиотики.
Удаление желез у котов
В запущенных случаях невозможно провести очистку воспаленных резервуаров, а промывание не дает должного эффекта. В такой ситуации проводят оперативное удаление содержимого мешочков. Накладывают швы, обрабатывают рану антисептиками, назначают противомикробные средства. Швы обрабатывают ранозаживляющей мазью, порошком или спреем.
Как помочь коту при воспалении параанальных желез в домашних условиях
Если проблемы не возникают вследствие врожденной предрасположенности, вина возлагается на владельца. Главная причина воспаления — неправильное кормление. Владельцы кошек пытаются сэкономить и варят питомцам суп из куриных лап и головок. Или угощают остатками со стола.
В результате развивается запоры или понос. Воспаляется прямая кишка, инфламмационный процесс распространяется на железы. Недостаток питья, особенно при скармливании готовых кормов эконом класса затрудняет прохождение пищи по кишечнику. Слизистая травмируется, воспаляется, страдают окружающие органы и ткани. Аналогичные повреждения вызывают гельминты. Поэтому ежеквартальная дегельминтизация — это один из способов профилактики парапроктита.
Ответственные владельцы кошек не дожидаются, когда железы воспалятся. Осваивают способы очистки. Ежеквартальная манипуляция сберегает здоровье питомца.
Инструкция
Показания к применению
Капли и спрей для носа рекомендуются при наличии следующих показаний:
- острый назофарингит,
- синусит,
- острый насморк (ринит).
Способ применения и дозировка
Препарат предназначен для интраназального применения (через носовую полость).
Детям от 3 до 6 лет рекомендуется капать 1-2 капли в каждый носовой ход 3 раза в день в течение недели (5-7 дней).
Для детей старше 6 лет и взрослых оптимальная дозировка составляет 2-3 капли с периодичностью, указанной выше.
Перед применением препарата ребенку необходимо сделать промывание носа.
Противопоказания
Основное противопоказание к лечению каплями в нос Сиалор для детей — индивидуальная непереносимость протеината серебра.
Для выявления реакции перед использованием лекарства от насморка рекомендуется провести тест: нужно капнуть немного раствора на кожу в области локтевого сгиба ребенка. Жжение и покраснение кожного покрова свидетельствуют о том, что капли противопоказаны к применению.
Обратите внимание: если во время лечения у малыша появляются побочные реакции в виде чувства сухости, жжения или раздражения в носу, использование препарата необходимо прекратить. Фармакологическое действие
Фармакологическое действие
Протеинат серебра, являющийся основным компонентом средства от насморка, оказывает выраженное обволакивающее, защитное и антисептическое воздействие на большинство болезнетворных бактерий, которые вызывают инфекционно-воспалительные заболевания верхних дыхательных путей. При этом протеинат серебра почти не проникает в кровь.
Полная инструкция СИАЛОР капли от насморка>>
Осложнения
При отсутствии лечения в таких обстоятельствах активно начинают размножаться и распространяться по организму болезнетворные бактерии. Одно из осложнений, которое появляется на запущенной стадии – абсцесс. Лечение питомца из-за такой патологии усложняется, и в конечном счете может потребоваться оперативное вмешательство – удаление абсцесса.
Другое осложнение, которое встречается немного реже – рак. Для подтверждения такого диагноза необходимо будет сдать ряд анализов. Активно в этом вопросе ветеринарным врачам помогает наука Гистология, позволяющая выявить наличие патологии в начале ее развития.
Как почистить железы самостоятельно
В домашних условиях чистить параанальные железы нужно в ванной комнате Лучше всего надеть защитную одежду, поскольку во время процедуры животное выделяет неприятно пахнущий секрет. Следует попросить кого-нибудь помочь, так как кошку нужно будет надежно зафиксировать. Существуют 3 способа очистки.
Способ первый представляет собой внешнее очищение. Изначально проводится дезинфекция рук. Затем, на параанальные железы кошки нужно нажать большим и указательным пальцами, выдавливая накопившуюся жидкость.
Второй метод почистить секреции — внутренняя чистка. Осуществляется в перчатках. Указательный палец вводится в анус животного. Снаружи большой палец массирует параанальные железы, чтобы отходил секрет. При этом способе выходит густая и вязкая жидкость.
Самый простой способ, которым можно в домашних условиях — это воспользоваться специальными средствами. Анус животного смазывают противовоспалительной мазью.
Как часто чистить железы
На вопрос о том, как часто проводить чистку, точно ответить нельзя, поскольку это зависит от животного. Иногда, требуется всего одно очищение, чтобы больше не возвращаться к этому вопросу, а порой процедуру приходится проводить несколько раз. Главное внимательно следить за животным и проводить профилактику заболевания.
Сколько стоит чистка параанальных желез у кошек — цена одного сеанса составляет примерно 300–500 рублей.
Промывание мешков
Данная процедура у кота не проводится без ветеринарных специалистов. Назначается она при осложнении или сильном воспалении. Процедуру проводят следующим образом:
- шприц без иголки наполняют асептическим раствором;
- раствор вводят в анальное отверстие кошки;
- манипуляции повторяют до тех пор, пока жидкость в мешочках не станет светлой;
- после чистки, в анус вводят антисептическую мазь.
Симптомы воспалительного процесса
При закупорке выводящих каналов изменяется концентрация и цвет выходящего секрета. Постепенно он становится гуще и темнее (вплоть до черного). В нем появляются творожистые вкрапления.
Из-за скапливающейся жидкости железы увеличиваются в размерах. Появившиеся уплотнения можно обнаружить при пальпации. Акт дефекации сопровождается болью, поэтому животное ведет себя беспокойно и постоянно вылизывает область ануса. Помимо болевого синдрома, возникает сильный зуд, который питомец пытается устранить катанием на попе. Этот симптом схож с глистной инвазией.
Частые вылизывания ухудшают состояние шерсти – она тускнеет и выпадает. Появляется перхоть и повышенная жирность. Поражается не только анальная область, но и прилегающие части: основание хвоста, крестец, внутренняя сторона задних лап.

Возникшие нарушения приводят к ухудшению аппетита и общего самочувствия. При присоединении вторичной инфекции возможно повышение температуры. Анальное отверстие опухает и выглядит грязным. Появляется неприятный запах, сохраняющийся даже после купания. Кот постоянно прикрывает анус хвостом, препятствуя пальпации. Возможно развитие хромоты.
При обнаружении перечисленных симптомов необходимо обследоваться у ветеринара. Своевременная диагностика исключит развитие осложнений.
Лечение отита
Если у Вас отит, лечение может назначить только врач-отоларинголог. Лечение отита зависит от стадии заболевания и состояния больного.
При остром евстахиите лечение отита направлено на восстановление функций слуховой трубы. Проводится санация околоносовых пазух, носа и носоглотки с целью устранения инфекции – ринита, синуита или др.).
Назначаются сосудосуживающие капли в нос (отривин, називин и т.д.), при обильном слизистом отделяемом из носа – препараты с вяжущим эффектом (колларгол, протаргол). Проводится катетеризация слуховой трубы с помощью водных растворов кортикостероидов, пневмомассаж барабанных перепонок.
В стадии острого катарального среднего отита катетеризация слуховой трубы проводится с введением в полость среднего уха водных растворов кортикостероидов и антибиотиков (пенициллины, цефалоспорины). Назначается местное обезболивание (капли отипакс, анауран, отинум). Проводится внутриушной эндауральный микрокомпресс по Цытовичу: в наружный слуховой проход вводят ватную или марлевую турунду, пропитанную препаратом с обезболивающим и дегидратирующим эффектом. Также назначают обезболивающие с жаропонижающим эффектом (нурофен, солпадеин и др). При отсутствии эффекта от симптоматической терапии в течение 48-72 часов назначается антибактериальная терапия.
Гнойный отит в до перфоративной острой стадии требует проведения такого же комплекса процедур, как и во второй стадии, однако дополненного следующими мерами:
- назначение антибиотиков пенициллинового ряда (амоксициллин и др.), цефалоспоринов или макролидов;
- парацентез (разрез барабанной перепонки) при появлении выбухания барабанной перепонки.
Важно не допустить на этой стадии осложнения заболевания. После самопроизвольного вскрытия барабанной перепонки или проведения парацентеза заболевание переходит в следующую стадию
Постперфоративная стадия острого гнойного среднего отита предполагает следующую схему лечения:
- продолжается начатая антибактериальная терапия;
- проводится катетеризации слуховой трубы с введением кортикостероидов и антибиотиков;
- ежедневно проводится тщательный туалет наружного слухового прохода – очистка его от гнойного содержимого;
- назначается транстимпанальное вливание капель с антибактериальным и противоотечным эффектом (капли на спиртовой основе (отипакс, 3% раствор борной кислоты) в данном случае не применяются).
В стадии рубцевания ОСО происходит самопроизвольное восстановление целостности перепонки, а также полностью восстанавливаются все функции уха. Однако этот период требует обязательного наблюдения у врача-отоларинголога: существует опасность хронизации воспаления в среднем ухе, перехода его в гнойную форму или развития адгезивного рубцового процесса в барабанной полости. Возможно также развитие мастоидита.
1
Аудиометрия в МедикСити
2
Аудиометрия в МедикСити
3
Аудиометрия в МедикСити
При остром среднем отите очень важно своевременное обращение к врачу-оториноларингологу. Единственной мерой профилактики осложнений являются правильные и своевременные диагностические и лечебные мероприятия при отите
Иногда последствиями острого среднего отита становятся спаечный процесс в барабанной полости (адгезивный средний отит), сухая перфорация в барабанной перепонке (сухой перфоративный средний отит), гнойная перфорация (хронический гнойный средний отит) и др. Кроме того, ОСО может привести к таким осложнениям, как мастоидит, лабиринтит, петрозит, менингит, сепсис, тромбоз венозного синуса, абсцесс мозга и другим угрожающим жизни пациента заболеваниям.
Виды корочек в носу
Корки, которые образуются в результате нарушения оттока слизи, различаются по цвету и плотности. Именно эти характеристики помогают определить, в чем причина нарушения носового дыхания.
Сухие корки в носу. Самые распространенные и часто встречающиеся у детей и взрослых
Обычно не привлекают внимание, если от них удается быстро избавиться. Белые сухие корки в носу у ребенка, особенно новорожденного, убираются во время утренних гигиенических процедур
Для этого используются ватные жгутики, которые можно обмакнуть в специальное детское масло, чтобы не повредить слизистую и не напугать ребенка. Если сухость и корки в носу начинают вызывать заметный дискомфорт, необходимо обратиться к врачу.
Кровянистые корки. Появляются вследствие постоянного или неаккуратного удаления сухих корок. Часто этим грешат дети и возрастные пациенты, которым не хватает терпения удалить сухие корки без последствий. Кровеносные капилляры не выдерживают резких механических повреждений и окрашивают корки в розово-красный цвет.
Желтые или зеленые корки в носу возникают вследствие развития бактериальной или вирусной инфекции. После лечения основного заболевания слизистые восстанавливаются и корочки пропадают.
Гнойные корки в носу. Их появление связано с проникновением в носовые ходы инфекции, чаще всего – стрептококка или стафилококка. Если слизистые были травмированы или пересушены, бактериальная атака ускоряется, что приводит к гнойный процессам.
Симптомы закупорки параанальной железы
В начальной стадии кошка начинает часто вылизывать под хвостом, беспокоится, ездит на попе по коврам и другим шероховатым поверхностям, от животного появляется неприятный запах.
По мере усугубления состояния развивается воспаление желез, что проявляется:
- Увеличением синусов, их болезненностью.
- Ухудшением аппетита.
- Вялостью животного.
- Развитием гнойных абсцессов с повышением температуры тела и общей интоксикацией.
Какие заболевания имеют схожую клиническую картину?
Симптом вылизывания заднего прохода и езды на попе характерен также для:
- Глистной инвазии.
- Аллергической реакции.
- Психо-неврологических расстройств животного.
- Стресса.
Диагностические методы
Диагноз ставится после проверки больного животного, оценки его состояния и характеристик выделяемого секрета. Специалист сдавливает параанальные железы, проводит забор секреторной жидкости. Стадия заболевания определяется цветом, консистенцией, количеством собранного материала.
Проводится бактериальный посев вещества на содержание патогенной микрофлоры. Процедура помогает определить резистентность бактерий к антибактериальным препаратам и подобрать схему лечения. Лабораторное изучение состава секрета проводится и в ходе терапии – для оценки ее эффективности.
Из-за чего появляются грибки?
Главная причина, связи с которой происходит увеличение численности грибка на теле – попадание в организм спор, что далее проявляется в качестве пятен в местах их локализации.
Ещё одной распространённой причиной является бытовой контакт с человеком, который заражен грибками. В качестве носителя инфекции могут выступать и питомцы.
Выделяются несколько механизмов, в процессе которых человек может заразиться:
- Через легкие и носоглотку. В этом случае он вдыхает микроорганизмы, которые через дыхательные пути проникают в кровь и поражают наиболее уязвимые участки.
- Проживание с зараженным человеком. Грибковые инфекции может передаваться через поцелуи и любые прикосновения к телу, а также при использовании общих бытовых объектов.
- Контакт с продуктами питания и жидкостями, которые содержат споры.
- Через повреждения кожи. Наличие ран увеличивает возможность подхватить микроорганизмы из внешней среды.
Основными причинами, связи с которыми человек может стать инфицированным грибковыми микроорганизмами, становятся следующие:
- Операции или тяжелые заболевания.
- Онкология и период химиотерапии.
- Серьезные сбои в системе обмена веществ.
- ВИЧ-инфекция.
- Наличие аутоиммунных болезней.
- Нарушение баланса микрофлоры кишечника и влагалища.
- Прием препаратов, содержащих гормоны.
В последние десятилетия врачи часто называют ещё одну причину заражения. Ей становится неконтролируемый прием антибактериальных препаратов среди населения, которые уменьшают сопротивление организма и существенно снижают иммунитет, нарушая микрофлору. Большинство людей занимаются самолечением, принимая антибиотики без показаний. На данный момент врачи при сезонных простудах и вирусных заболеваниях не выписывают антибактериальные препараты, так как организм человека имеет все возможности, чтобы справиться с бактериями самостоятельно. Бесконтрольный прием антибиотиков бьёт по кишечнику, который отвечает за иммунную систему, а также вызывает эндокринные нарушения и способствует обострению хронических болезней. На фоне последствий от таблеток организм не может справляться с грибками, которые накапливаются и поражают органы.
Выделяют несколько внешних причин, которые также могут провоцировать заражение:
- Недостаточное проведение процедур личной гигиены.
- Лишний вес и усиленная работа сальных желёз.
- Отсутствие лечения микротравм и ран.
- Частые стрессы и утомляемость.
- Несбалансированное питание и злоупотребление вредной пищей.
- Наличие предрасположенности к микозу.
- Беременность.
Все вышеперечисленные причины создают общий фактор, в связи с которым организм становится более уязвимым и подверженным к заражению грибками, бактериями и вирусами – снижение защитных функций иммунной системы.
КАК ПРАВИЛЬНО ЧИСТИТЬ ПАРААНАЛЬНЫЕ ЖЕЛЕЗЫ?
Данная процедура не относится к приятным, но с ее помощью можно устранить серьезную проблему. Для ее осуществления следует предпринять такие действия:
- Поставить кошку в ванную. По окончании процедуры можно будет легко смыть все результаты. Можно это делать на полу, предварительно застелив его клеенкой;
- Надеть перчатки, подготовить бумажные полотенца, чтобы убирать выделения;
- Стать сбоку от кошки, поднять одной рукой хвост, другой взять полотенце;
- Правильно установить пальцы. Если представить часовой циферблат, то расположение анальных желез у кошки будет на цифрах 4 и 8 .
Воспаленные анальные железы легко прощупать, ведь они выглядят как два узла различных размеров, но в основном не очень больших.
Узелки сжимаются пальцами, при этом задействуются большой и указательный. Нужно следить за тем, чтобы анус закрывало полотенце. Опустошение желез чувствуется под пальцами
. Выделения при чистке могут быть как вязкими, так и жидкими.
Видео: зачем чистить анальные железы?
Профилактика заболеваний
Здоровье кошки полностью зависит от ее владельца. Поэтому ему необходимо быть полностью осведомленным об опасностях, которые может повлечь за собой заболевание и по возможности предотвращать их возникновение. Так, профилактикой закупорки параанальных желез является проведение регулярной их чистки руками.
Специалистами рекомендуется осуществление данной процедуры не менее одного раза в несколько месяцев. Следует помнить так же о том, что далеко не каждая кошка постоянно испытывает в этом потребность
И если владелец регулярно приносит свое животное на плановые осмотры в ветеринарную клинику, то специалист должен обязательно обратить внимание, в каком состоянии находятся железы. Иногда приходится об этом просить или напоминать, но лучше убедиться заранее, что кошка полностью здорова
Дома нужно совершать гигиенические процедуры, заключающиеся в промывании ануса водой с разведенным в ней мылом
Это применяется в качестве дополнительной стимуляции, оказывающей положительное влияние на самостоятельную очистку параанальных желез у кошки
Дома нужно совершать гигиенические процедуры, заключающиеся в промывании ануса водой с разведенным в ней мылом. Это применяется в качестве дополнительной стимуляции, оказывающей положительное влияние на самостоятельную очистку параанальных желез у кошки.
Если необходимо прибегнуть к ручной чистке, но владелец не обладает должным опытом, или попросту боится это делать сам, можно обратиться к грумеру.
Существует очень много видеоматериалов, касающихся ручной чистке параанальных желез в интернет-сети, однако специалистами не рекомендуется осуществлять это в домашних условиях из-за присутствия у выделений очень неприятного запаха и риска запачкать в квартире мебель. Плюс ко всему, для кошки процедура является болезненной
и животное способно проявить неадекватное поведение и травмировать владельца.
Если у вас есть вопросы, оставьте их ниже — мы обязательно ответим вам!
К сожалению, у кошек часто возникают проблемы с выделительной системой. Эти патологии наносят вред питомцу и очень опасны для него. К ним относится и воспаление параанальных желез у кошек. Заботливый хозяин по поведению питомца может понять, что с ним что-то происходит не так. Зная причины и симптомы заболевания можно исключить этот недуг.
Узнать воспаление параанальных желез можно по следующим симптомам:
- Кошка ерзает задней частью по полу.
- Нервно грызет кончик хвоста.
- Усиленно вылизывает участок ануса.
- У животного возможно появление зуда по всему телу.
- В более тяжелых случаях у кота появляется крайне болезненный абсцесс под хвостиком, который мешает нормально сходить в туалет.
- В дальнейшем абсцесс причиняет сильную боль и в спокойном состоянии.
- От питомца идет крайне неприятный запах.
- Во время надавливания на область ануса появляются неприятно пахнущие вязкие капли темного цвета.




































